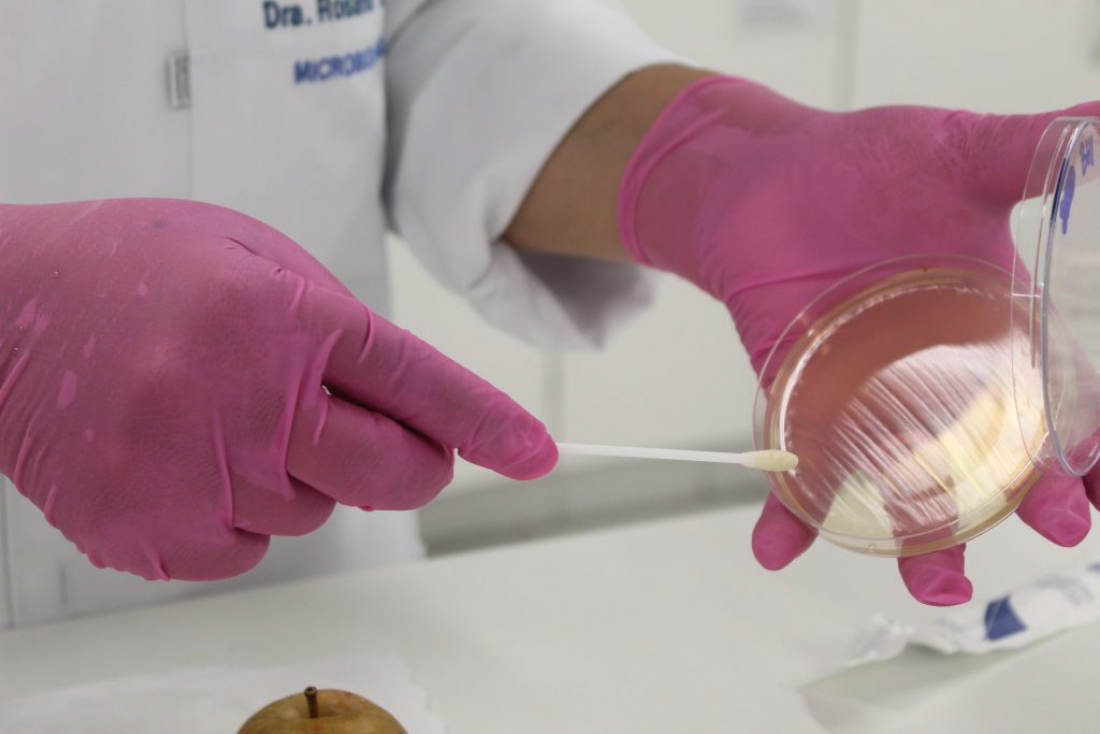
Saúde: Bactérias do intestino podem ser causa de asma e alergias, aponta estudo

Quinta, 12 de março de 2026
48 3191-0403
A asma e as alergias são problemas de saúde extremamente comuns nas crianças e responsáveis por grandes desconfortos por toda a vida. Em busca de uma maneira de combater essas enfermidades com mais eficácia, um grupo de cientistas americanos resolveu investigar as origens delas.
Em estudo com recém-nascidos, a equipe identificou um composto produzido por bactérias intestinais que se mostrou forte influenciador do surgimento de ambas as complicações. Os especialistas acreditam que os novos dados poderão ajudar no combate a essas doenças.
Em estudos anteriores, os cientistas analisaram bebês com 1 mês de idade e observaram que aqueles com ecossistemas microbianos intestinais insalubres (não tão diversos) apresentavam maior risco de desenvolver asma na infância. A equipe também detectou que a molécula lipídica chamada 12,13-diHOME, liberada por bactérias, quando encontrada em altas concentrações nas fezes dos recém-nascidos, reduzia o número e a atividade de um grupo-chave de células imunes, as T reguladoras (Tregs). Segundo os especialistas, as Tregs normalmente suprimem a inflamação alérgica.
No estudo atual, publicado na revista Nature Microbiology, os cientistas injetaram 12,13-diHOME no intestino de camundongos, o que reduziu o número de células Treg nos pulmões dos animais, comprometendo funções das células imunológicas. Para entender de onde vinha esse lipídio pró-inflamatório, os pesquisadores estudaram os genes microbianos presentes nas amostras de fezes de 41 bebês de etnias diversas e com 1 mês de nascidos.
Nas análises, descobriram que o número de cópias de três genes de 12,13 DiHOME ou a concentração do próprio lipídio nas amostras de fezes dos bebês ajudou a prever quais as crianças desenvolveriam alergia aos 2 anos de idade ou asma aos 4. “Descobrimos um lipídio bacteriano específico no intestino neonatal que promove a disfunção imunológica associada à asma alérgica e pode ser usado para avaliar quais bebês estão em risco de desenvolver a doença na infância”, explica, em comunicado, Susan Lynch, uma das autoras do estudo e pesquisadora da Universidade da Califórnia.
Os pesquisadores enfatizam, no estudo, que a molécula 2,13-diHOME é provavelmente apenas um dos muitos produtos derivados de micro-organismos que contribuem para a disfunção imunológica precoce e a suscetibilidade à alergia infantil e à asma. “Esse é provavelmente apenas um componente de uma complexa interação microbiana/sistema imune em crianças pequenas que promove o desenvolvimento de alergia e asma na infância. Mas é um primeiro passo para uma compreensão mais mecanicista do conjunto de produtos microbianos que aumentam essa suscetibilidade”, frisa Susan Lynch.
